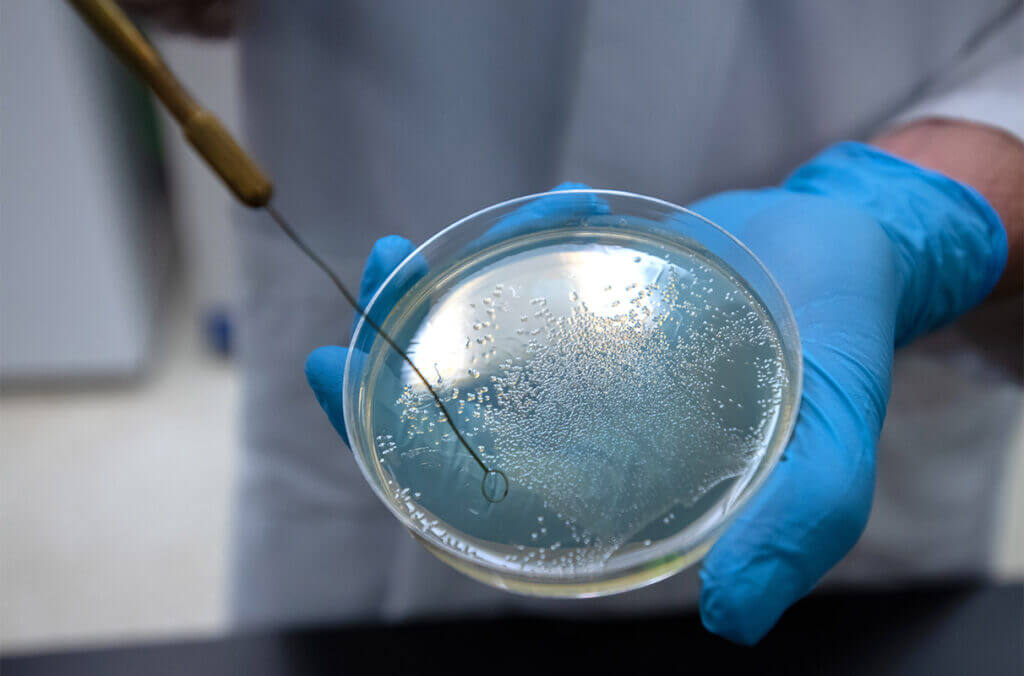
A petri dish containing salmonella bacteria.

(Credit: © Natalia Skripnikova | Dreamstime.com)
In a nutshell
- Researchers found that household dogs can carry and spread antibiotic-resistant Salmonella bacteria even when appearing perfectly healthy, with 39% of infected dogs harboring genes that allow for extended bacterial shedding.
- The study identified 16 human Salmonella infections closely related to dog-associated strains, suggesting possible transmission between pets and their owners through everyday contact and improper hygiene.
- While pet ownership offers many health benefits, simple practices like proper hand washing and food handling can help protect both humans and their canine companions from spreading dangerous bacteria.
39% of healthy dogs may silently carry dangerous Salmonella strains, researchers warn
UNIVERSITY PARK, Pa. — Next time your furry friend gives you those irresistible puppy dog eyes, you might want to think twice before sharing your snack. That’s because scientists say that household dogs could be silent carriers of dangerous antibiotic-resistant Salmonella bacteria, potentially putting their human families at risk.
Most pet owners know to wash their hands after handling raw pet food or cleaning up after their dogs, but researchers at Pennsylvania State University have uncovered a concerning trend: household dogs can carry and spread drug-resistant strains of Salmonella even when they appear perfectly healthy. This finding is particularly worrisome because these resistant bacteria can make treating infections much more challenging in both animals and humans.
The research takes on added significance considering that over half of U.S. homes include dogs. “We have this close bond with companion animals in general, and we have a really close interface with dogs,” explains Sophia Kenney, the study’s lead author and doctoral candidate at Penn State, in a statement. “We don’t let cows sleep in our beds or lick our faces, but we do dogs.”

To investigate this concerning possibility, the research team employed a clever detective-like approach. They first tapped into an existing network of veterinary laboratories that regularly test animals for various diseases. They identified 87 cases where dogs had tested positive for Salmonella between May 2017 and March 2023. These weren’t just random samples: they came from real cases where veterinarians had submitted samples for testing, whether the dogs showed symptoms or not.
The scientists then did something akin to matching fingerprints. For each dog case they found, they searched a national database of human Salmonella infections, looking for cases that occurred in the same geographic areas around the same times. This database, maintained by the National Institutes of Health, is like a library of bacterial information collected from patients across the country. Through this matching process, they identified 77 human cases that could potentially be connected to the dog infections.
The research team then used advanced DNA sequencing technology to analyze each bacterial sample. This allowed them to not only identify different varieties of Salmonella but also determine how closely related the bacteria from dogs were to those found in humans. They specifically looked for two key things: genes that make the bacteria resistant to antibiotics, and genes that help the bacteria cause disease.

What they found was eye-opening. Among the dog samples, they discovered 82 cases of the same type of Salmonella that commonly causes human illness. More concerning was that many of these bacterial strains carried genes making them resistant to important antibiotics, the same medicines doctors rely on to treat serious infections.
In particular, 16 of the human cases were found to be very closely related to six different dog-associated strains. While this doesn’t definitively prove the infections spread from dogs to humans, it’s like finding matching puzzle pieces that suggest a connection. The researchers also discovered that 39% of the dog samples contained a special gene called shdA, which allows the bacteria to survive longer in the dog’s intestines. This means infected dogs could potentially spread the bacteria through their waste for extended periods without appearing sick themselves.
The bacteria showed impressive diversity, with researchers identifying 31 different varieties in dogs alone. Some common types found in both dogs and humans included strains known as Newport, Typhimurium, and Enteritidis — names that might not mean much to the average person but are well-known to health officials for causing human illness.
The research has highlighted real-world implications. Study co-author Nkuchia M’ikanatha, lead epidemiologist for the Pennsylvania Department of Health, points to a recent outbreak where pig ear pet treats sickened 154 people across 34 states with multidrug-resistant Salmonella. “This reminds us that simple hygiene practices such as hand washing are needed to protect both our furry friends and ourselves — our dogs are family but even the healthiest pup can carry Salmonella,” he notes.
The historical context adds another layer to the findings. According to researchers, Salmonella has been intertwined with human history since agriculture began, potentially shadowing humanity for around 10,000 years alongside animal domestication.
While the study reveals concerning patterns about antibiotic resistance and disease transmission, lead researcher Erika Ganda emphasizes that not all bacteria are harmful. “Bacteria are never entirely ‘bad’ or ‘good’ — their role depends on the context,” she explains. “While some bacteria, like Salmonella, can pose serious health risks, others are essential for maintaining our health and the health of our pets.”

Of course, this doesn’t mean we should reconsider having dogs as pets. Instead, scientists say just be smart, and maybe try not to let your pooch kiss you on the lips.
“Several studies highlight the significant physical and mental health benefits of owning a dog, including reduced stress and increased physical activity,” Ganda notes. “Our goal is not to discourage pet ownership but to ensure that people are aware of potential risks and take simple steps, like practicing good hygiene, to keep both their families and their furry companions safe.”
Paper Summary
Methodology
Researchers used advanced genetic sequencing techniques to analyze Salmonella samples from both dogs and humans. They identified dog-associated samples through veterinary networks and matched them with human samples from the same regions and time periods. The team then compared genetic patterns, antibiotic resistance genes, and virulence factors between the samples to understand their relationships and potential health impacts.
Results
The study analyzed 87 dog samples and 77 human samples across 17 states. Of the dog samples, 82 belonged to the most common Salmonella subspecies found in humans. The bacteria showed resistance to multiple important antibiotic classes, and 16 human infections were closely related to six dog-associated strains. Additionally, 39% of dog samples contained genes allowing for prolonged bacterial shedding.
Limitations
The research team acknowledged that their sample selection had inherent biases, as they only analyzed samples from dogs that had undergone veterinary testing. This means the study can’t make broad claims about Salmonella prevalence in the general dog population. Additionally, the matching of dog and human samples doesn’t prove direct transmission between pets and owners.
Discussion and Takeaways
The study emphasizes three main points: the need for better surveillance of antibiotic resistance in companion animals, the importance of proper hygiene around pets, and the critical role of responsible antibiotic use in both human and veterinary medicine. The findings support expanding health monitoring programs to include pets alongside traditional agricultural and human health surveillance.
The research gains particular relevance given the widespread presence of dogs in American households, with over half of U.S. homes including canine companions. The historical relationship between humans and Salmonella, dating back approximately 10,000 years to the dawn of agriculture, provides important context for understanding current challenges in disease prevention and control.
Funding and Disclosures
This research received support from several major U.S. government agencies, including the Department of Agriculture, Centers for Disease Control and Prevention, National Institutes of Health, and Food and Drug Administration. The authors declared no conflicts of interest.
Publication Information
This study, titled “Antimicrobial Resistance and Zoonotic Potential of Nontyphoidal Salmonella From Household Dogs,” was published in Zoonoses and Public Health, Volume 72, pages 84-94, 2025 (https://doi.org/10.1111/zph.13174).







